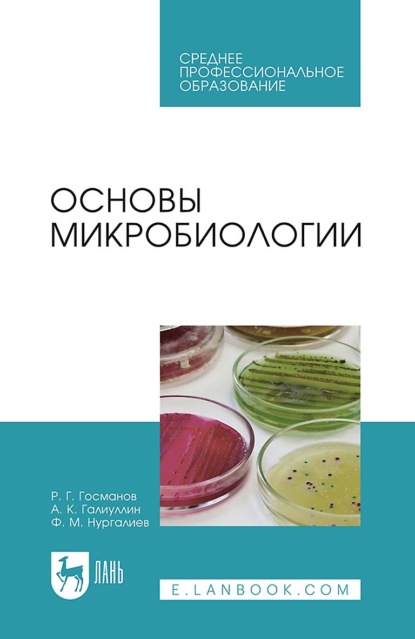
img

Микология и микотоксикология
В монографии рассмотрены вопросы общей микологии и микотоксикологии, изложены актуальные проблемы современной микологии, а также классификации микроскопических грибов, условия пребывания и жизнеспособности их во внешней среде. Материалы по болезням изложены по единой схеме и включают поражение кормов микроскопическими грибами, определение болезни, характеристику возбудителя, основные эпизоотологические данные, характер течения и клинические формы проявления болезни, методы диагностики, лечение и профилактика, основные оздоровительные мероприятия. Описаны наиболее распространенные микозы и микотоксикозы животных. Монография предназначена практикующим ветеринарным врачам, работникам ветеринарных лабораторий, научно-исследовательских учреждений, аспирантам, студентам вузов, интересующимся вопросами патологии и эпизоотологии микозов и микотоксикозов у животных и человека.